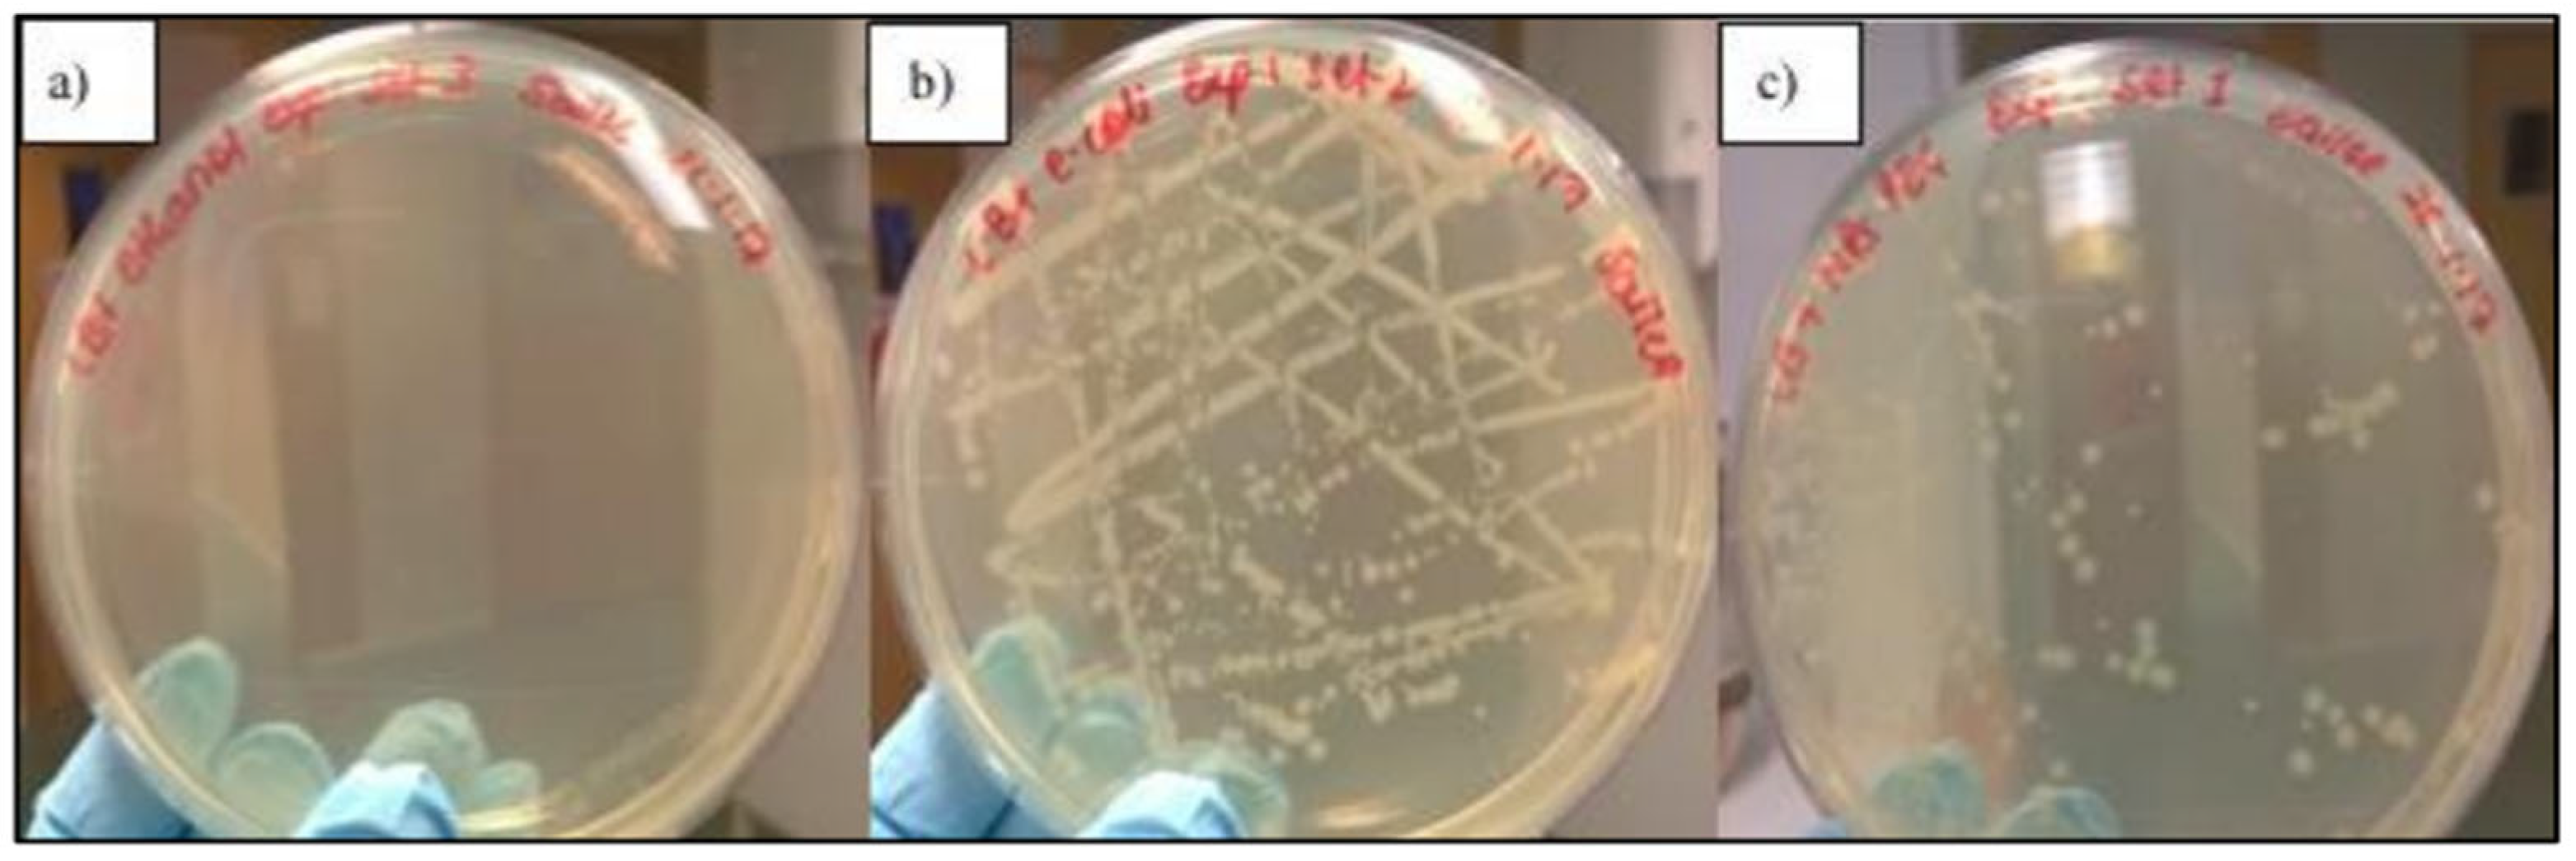

Biogenic Synthesis of Silver Nanoparticles and Their Diverse Biomedical Applications
Abstract
1. Introduction
1.1. Background: Nanoparticles in Biomedical Applications
1.2. Emergence of Biogenically Synthesised Nanoparticles
1.3. Scope and Objectives of the Review
2. Biogenic Synthesis of AgNPs
2.1. Biological Sources
2.2. Routes of Biogenic Synthesis
2.2.1. Plant-Mediated Synthesis
2.2.2. Microbial-Based Synthesis (Bacteria, Fungi, Algae)
2.2.3. Biomolecule-Based Synthesis (Proteins, Enzymes, Polysaccharides)
2.3. Process Optimisation of Biogenetic Synthesis
2.3.1. Incubation Time
2.3.2. Media Composition
2.3.3. Temperature
2.3.4. Aerobicity
2.3.5. pH
3. Mechanisms of AgNPs Biosynthesis
3.1. Adaptive Nano Biogenesis
3.2. Development of Bacterial Resistance by Effluxing
3.3. Intracellular and Extracellular Biosynthetic Pathways to AgNPs
4. Strategic Design of NPs’ Size and Shape for Enhanced Performance
4.1. Impact of AgNPs’ Shape and Crystallographic Facets on Antibacterial Activity
4.2. Crystallographic Facets and Surface Reactivity
4.3. Size-Dependent Antibacterial Activity and Surface Area Effects
4.4. Mechanistic Insights into Bactericidal Activity
5. Biomedical Applications of Biogenically Synthesised AgNPs
5.1. Synergistic Effects on Antibiotics
5.2. Anticancer Applications
5.3. Roles in Targeted Drug Delivery
5.4. Next-Generation Biomedical Applications Enabled by AgNPs
5.5. Toxicological Impacts of AgNPs on Human Health
6. Concluding Remarks
7. Future Prospects and Industrial Challenges in the Biological Synthesis of AgNPs
Author Contributions
Funding
Institutional Review Board Statement
Informed Consent Statement
Data Availability Statement
Conflicts of Interest
References
- Peer, D.; Karp, J.M.; Hong, S.; Farokhzad, O.C.; Margalit, R.; Langer, R. Nanocarriers as an emerging platform for cancer therapy. Nat. Nanotechnol. 2007, 2, 751–760. [Google Scholar] [CrossRef] [PubMed]
- Kurul, F.; Turkmen, H.; Cetin, A.E.; Topkaya, S.N. Nanomedicine: How nanomaterials are transforming drug delivery, bio-imaging, and diagnosis. Next Nanotechnol. 2025, 7, 100129. [Google Scholar] [CrossRef]
- Bamrungsap, S.; Zhao, Z.; Chen, T.; Wang, L.; Li, C.; Fu, T.; Tan, W. Nanotechnology in therapeutics: A focus on nanoparticles as a drug delivery system. Nanomedicine 2012, 7, 1253–1271. [Google Scholar] [CrossRef] [PubMed]
- Barenholz, Y. Doxil®–The first FDA-approved nano-drug: Lessons learned. J. Control. Release 2012, 160, 117–134. [Google Scholar] [CrossRef] [PubMed]
- Maeda, H. The 35th anniversary of the discovery of EPR effect: A new wave of nanomedicines for tumor-targeted drug delivery-personal remarks and future prospects. J. Pers. Med. 2021, 11, 229. [Google Scholar] [CrossRef] [PubMed]
- Lin, W. Introduction: Nanoparticles in Medicine. Chem. Rev. 2015, 115, 10407–10409. [Google Scholar] [CrossRef] [PubMed]
- Iravani, S.; Korbekandi, H.; Mirmohammadi, S.V.; Zolfaghari, B. Synthesis of silver nanoparticles: Chemical, physical and biological methods. Res. Pharm. Sci. 2014, 9, 385–406. Available online: https://pmc.ncbi.nlm.nih.gov/articles/PMC4326978/ (accessed on 8 May 2025). [PubMed]
- Gupta, D.; Boora, A.; Thakur, A.; Gupta, T.K. Green and sustainable synthesis of nanomaterials: Recent advancements and limitations. Environ. Res. 2023, 231, 116316. [Google Scholar] [CrossRef] [PubMed]
- Farjadian, F.; Ghasemi, A.; Gohari, O.; Roointan, A.; Karimi, M.; Hamblin, M.R. Nanopharmaceuticals and nanomedicines currently on the market: Challenges and opportunities. Nanomedicine 2019, 14, 93–126. [Google Scholar] [CrossRef] [PubMed]
- Patil, S.; Chandrasekaran, R. Biogenic nanoparticles: A comprehensive perspective in synthesis, characterization, application and its challenges. J. Genet. Eng. Biotechnol. 2020, 18, 67. [Google Scholar] [CrossRef] [PubMed]
- Mughal, B.; Zaidi, S.Z.J.; Zhang, X.; Hassan, S.U. Biogenic Nanoparticles: Synthesis, Characterisation and Applications. Appl. Sci. 2021, 11, 2598. [Google Scholar] [CrossRef]
- Ahmed, S.; Ahmad, M.; Swami, B.L.; Ikram, S. A review on plants extract mediated synthesis of silver nanoparticles for antimicrobial applications: A green expertise. J. Adv. Res. 2016, 7, 17–28. [Google Scholar] [CrossRef] [PubMed]
- Hulkoti, N.I.; Taranath, T.C. Biosynthesis of nanoparticles using microbes-A review. Colloids Surf. B Biointerfaces 2014, 121, 474–483. [Google Scholar] [CrossRef] [PubMed]
- Barbinta-Patrascu, M.E.; Gorshkova, Y.; Ungureanu, C.; Badea, N.; Bokuchava, G.; Lazea-Stoyanova, A.; Bacalum, M.; Zhigunov, A.; Petrovic, S. Characterization and antitumoral activity of biohybrids based on turmeric and silver/silver chloride nanoparticles. Materials 2021, 14, 4726. [Google Scholar] [CrossRef] [PubMed]
- Harutyunyan, A.; Gabrielyan, L.; Aghajanyan, A.; Gevorgyan, S.; Schubert, R.; Betzel, C.; Kujawski, W.; Gabrielyan, L. Comparative Study of Physicochemical Properties and Antibacterial Potential of Cyanobacteria Spirulina platensis -Derived and Chemically Synthesized Silver Nanoparticles. ACS Omega 2024, 9, 29410–29421. [Google Scholar] [CrossRef] [PubMed]
- Kumar, M.N.V.R. A review of chitin and chitosan applications. React. Funct. Polym. 2000, 46, 1–27. [Google Scholar] [CrossRef]
- Elsadek, B.; Kratz, F. Impact of albumin on drug delivery–New applications on the horizon. J. Control. Release 2012, 157, 4–28. [Google Scholar] [CrossRef] [PubMed]
- Toscano, F.; Torres-Arias, M. Nanoparticles cellular uptake, trafficking, activation, toxicity and in vitro evaluation. Curr. Res. Immunol. 2023, 9, 100073. [Google Scholar] [CrossRef] [PubMed]
- Aldakheel, F.M.; Sayed, M.M.E.; Mohsen, D.; Fagir, M.H.; El Dein, D.K. Green Synthesis of Silver Nanoparticles Loaded Hydrogel for Wound Healing; Systematic Review. Gels 2023, 9, 530. [Google Scholar] [CrossRef] [PubMed]
- Patra, C.R.; Mukherjee, S.; Kotcherlakota, R. Biosynthesized Silver Nanoparticles: A Step Forward for Cancer Theranostics? Nanomedicine 2014, 9, 1445–1448. [Google Scholar] [CrossRef] [PubMed]
- Mabey, T.; Cristaldi, D.A.; Oyston, P.; Lymer, K.P.; Stulz, E.; Wilks, S.; Keevil, C.W.; Zhang, X. Bacteria and nanosilver: The quest for optimal production. Crit. Rev. Biotechnol. 2019, 39, 272–287. [Google Scholar] [CrossRef] [PubMed]
- Dhir, R.; Chauhan, S.; Subham, P.; Kumar, S.; Sharma, P.; Shidiki, A.; Kumar, G. Plant-mediated synthesis of silver nanoparticles: Unlocking their pharmacological potential—A comprehensive review. Front. Bioeng. Biotechnol. 2024, 11, 1324805. [Google Scholar] [CrossRef] [PubMed]
- Ijaz, I.; Bukhari, A.; Gilani, E.; Nazir, A.; Zain, H.; Saeed, R.; Hussain, S.; Hussain, T.; Bukhari, A.; Naseer, Y.; et al. Green synthesis of silver nanoparticles using different plants parts and biological organisms, characterization and antibacterial activity. Environ. Nanotechnol. Monit. Manag. 2022, 18, 100704. [Google Scholar] [CrossRef]
- Makarov, V.V.; Love, A.J.; Sinitsyna, O.V.; Makarova, S.S.; Yaminsky, I.V.; Taliansky, M.E.; Kalinina, N.O. ‘Green’ Nanotechnologies: Synthesis of Metal Nanoparticles Using Plants. Acta Naturae 2014, 6, 35–44. [Google Scholar] [CrossRef] [PubMed]
- Vimal, A.; Aditya, S.; Kavipraba, A. Exploring Microbial Nanoparticle Biosynthesis and Its Impact. Environ. Qual. Manag. 2025, 34, e70093. [Google Scholar] [CrossRef]
- Gautam, D.; Dolma, K.G.; Khandelwal, B.; Gupta, M.; Singh, M.; Mahboob, T.; Teotia, A.; Thota, P.; Bhattacharya, J.; Goyal, R.; et al. Green synthesis of silver nanoparticles using Ocimum sanctum Linn. and its antibacterial activity against multidrug resistant Acinetobacter baumannii. PeerJ 2023, 11, e15590. [Google Scholar] [CrossRef] [PubMed]
- Golpour, M.; Ebrahimnejad, P.; Gatabi, Z.R.; Najafi, A.; Davoodi, A.; Khajavi, R.; Alimohammadi, M.; Mousavi, T. Green tea-mediated synthesis of silver nanoparticles: Enhanced anti-cancer activity and reduced cytotoxicity melanoma and normal murine cell lines. Inorg. Chem. Commun. 2024, 161, 111989. [Google Scholar] [CrossRef]
- Sastry, M.; Ahmad, A.; Khan, M.I.; Kumar, R. Biosynthesis of metal nanoparticles using fungi and actinomycete. Curr. Sci. 2003, 85, 162–170. Available online: http://repository.ias.ac.in/47133/1/92_pub.pdf (accessed on 8 May 2025).
- Hamida, R.S.; Ali, M.A.; Alkhateeb, M.A.; Alfassam, H.E.; Momenah, M.A.; Bin-Meferij, M.M. Algal-Derived Synthesis of Silver Nanoparticles Using the Unicellular ulvophyte sp. MBIC10591: Optimisation, Characterisation, and Biological Activities. Molecules 2022, 28, 279. [Google Scholar] [CrossRef] [PubMed]
- Saxena, J.; Sharma, P.K.; Sharma, M.M.; Singh, A. Process optimization for green synthesis of silver nanoparticles by Sclerotinia sclerotiorum MTCC 8785 and evaluation of its antibacterial properties. Springerplus 2016, 5, 861. [Google Scholar] [CrossRef] [PubMed]
- Zhang, Y.; Larionov, K.S.; Zhang, S.; Sobolev, N.A.; Konstantinov, A.I.; Volkov, D.S.; Suslova, E.V.; Chernov, V.E.; Poloskov, A.I.; Glushakov, R.I.; et al. Humic Polyelectrolytes Facilitate Rapid Microwave Synthesis of Silver Nanoparticles Suitable for Wound-Healing Applications. Polymers 2024, 16, 587. [Google Scholar] [CrossRef] [PubMed]
- Pandit, C.; Roy, A.; Ghotekar, S.; Khusro, A.; Islam, M.N.; Bin Emran, T.; Lam, S.E.; Khandaker, M.U.; Bradley, D.A. Biological agents for synthesis of nanoparticles and their applications. J. King Saud. Univ. Sci. 2022, 34, 101869. [Google Scholar] [CrossRef]
- Uthra, C.; Muralitharan, G.; Nagaraj, K.; Thajjudin, N.; Kaliyaperumal, R.; Badgujar, N.P.; Shah, F.; Abhijith, S.M. Exploring biogenic microbial synthesis and biomedical applications of silver nanoparticles: A comprehensive review. Results Chem. 2024, 8, 101555. [Google Scholar] [CrossRef]
- Shivaji, S.; Madhu, S.; Singh, S. Extracellular synthesis of antibacterial silver nanoparticles using psychrophilic bacteria. Process Biochem. 2011, 46, 1800–1807. [Google Scholar] [CrossRef]
- Elamawi, R.M.; Al-Harbi, R.E.; Hendi, A.A. Biosynthesis and characterization of silver nanoparticles using Trichoderma longibrachiatum and their effect on phytopathogenic fungi. Egypt J. Biol. Pest Control 2018, 28, 28. [Google Scholar] [CrossRef]
- Rudakiya, D.M.; Pawar, K. Bactericidal potential of silver nanoparticles synthesized using cell-free extract of Comamonas acidovorans: In vitro and in silico approaches. 3 Biotech 2017, 7, 92. [Google Scholar] [CrossRef] [PubMed]
- Zhang, H.; Li, Q.; Wang, H.; Sun, D.; Lu, Y.; He, N. Accumulation of silver(I) ion and diamine silver complex by Aeromonas SH10 biomass. Appl. Biochem. Biotechnol 2007, 143, 54–62. [Google Scholar] [CrossRef] [PubMed]
- Ramanathan, R.K.; O’Mullane, A.P.; Parikh, R.Y.; Smooker, P.M.; Bhargava, S.K.; Bansal, V. Bacterial Kinetics-Controlled Shape-Directed Biosynthesis of Silver Nanoplates Using Morganella psychrotolerans. Langmuir 2010, 27, 714–719. [Google Scholar] [CrossRef] [PubMed]
- Solís-Sandí, I.; Cordero-Fuentes, S.; Pereira-Reyes, R.; Vega-Baudrit, J.R.; Batista-Menezes, D.; Montes, G. Optimization of the biosynthesis of silver nanoparticles using bacterial extracts and their antimicrobial potential. Biotechnol. Rep. 2023, 40, e00816. [Google Scholar] [CrossRef] [PubMed]
- Gurunathan, S.; Kalishwaralal, K.; Vaidyanathan, R.; Deepak, V.; Pandian, S.R.K.; Muniyandi, J.; Hariharan, N.; Eom, S.H. Biosynthesis, purification and characterization of silver nanoparticles using Escherichia coli. Colloids Surf. B Biointerfaces 2009, 74, 328–335. [Google Scholar] [CrossRef] [PubMed]
- Saifuddin, N.; Wong, C.W.; Yasumira, A.A.N. Rapid Biosynthesis of Silver Nanoparticles Using Culture Supernatant of Bacteria with Microwave Irradiation. E-J. Chem. 2009, 6, 61–70. [Google Scholar] [CrossRef]
- Płaza, G.A.; Chojniak, J.; Mendrek, B.; Trzebicka, B.; Kvitek, L.; Panacek, A.; Prucek, R.; Zboril, R.; Paraszkiewicz, K.; Bernat, P. Synthesis of silver nanoparticles by Bacillus subtilis T-1 growing on agro-industrial wastes and producing biosurfactant. IET Nanobiotechnol 2016, 10, 62–68. [Google Scholar] [CrossRef] [PubMed]
- Klaus, T.; Joerger, R.; Olsson, E.; Granqvist, C.-G. Silver-based crystalline nanoparticles, microbially fabricated. Proc. Natl. Acad. Sci. USA 1999, 96, 13611–13614. [Google Scholar] [CrossRef] [PubMed]
- Zhang, H.; Li, Q.B.; Lu, Y.H.; Sun, D.H.; Lin, X.P.; Deng, X.; He, N.; Zheng, S.Z. Biosorption and bioreduction of diamine silver complex by Corynebacterium. J. Chem. Technol. Biotechnol. 2005, 80, 285–290. [Google Scholar] [CrossRef]
- Vanlalveni, C.; Ralte, V.; Zohmingliana, H.; Das, S.; Anal, J.M.H.; Lallianrawna, S.; Rokhum, S.L. A review of microbes mediated biosynthesis of silver nanoparticles and their enhanced antimicrobial activities. Heliyon 2024, 10, e32333. [Google Scholar] [CrossRef] [PubMed]
- Javani, S.; Marín, I.; Amils, R.; Abad, J.P. Four psychrophilic bacteria from Antarctica extracellularly biosynthesize at low temperature highly stable silver nanoparticles with outstanding antimicrobial activity. Colloids Surf. A Physicochem. Eng. Asp. 2015, 483, 60–69. [Google Scholar] [CrossRef]
- Parikh, R.Y.; Ramanathan, R.; Coloe, P.J.; Bhargava, S.K.; Patole, M.S.; Shouche, Y.S.; Bansal, V. Genus-Wide Physicochemical Evidence of Extracellular Crystalline Silver Nanoparticles Biosynthesis by Morganella spp. PLoS ONE 2011, 6, e21401. PLoS ONE 2011, 6, e21401. [Google Scholar] [CrossRef] [PubMed]
- Alamri, S.A.M.; Hashem, M.; Nafady, N.A.; Sayed, M.A.; Alshehri, A.M.; Alshaboury, G.A. Controllable biogenic synthesis of intracellular silver/silver chloride nanoparticles by Meyerozyma guilliermondii KX008616. J. Microbiol. Biotechnol. 2018, 28, 917–930. [Google Scholar] [CrossRef] [PubMed]
- Bharti, S.; Mukherji, S.; Mukherji, S. Extracellular synthesis of silver nanoparticles by Thiosphaera pantotropha and evaluation of their antibacterial and cytotoxic effects. 3 Biotech 2020, 10, 237. [Google Scholar] [CrossRef] [PubMed]
- Al-asbahi, M.G.S.S.; Al-Ofiry, B.A.; Saad, F.A.A.; Alnehia, A.; Al-Gunaid, M.Q.A. Silver nanoparticles biosynthesis using mixture of Lactobacillus sp. and Bacillus sp. growth and their antibacterial activity. Sci. Rep. 2024, 14, 10224. [Google Scholar] [CrossRef] [PubMed]
- Karthik, C.; Radha, K. BIOSYNTHESIS AND CHARACTERIZATION OF SILVER NANOPARTICLES USING ENTEROBACTER AEROGENES: A KINETIC APPROACH. Dig. J. Nanomater Biostruct 2012, 7, 1007–1014. Available online: https://www.chalcogen.ro/1007_Kartick.pdf (accessed on 8 May 2025).
- Abd-Elnaby, H.M.; Abo-Elala, G.M.; Abdel-Raouf, U.M.; Hamed, M.M. Antibacterial and anticancer activity of extracellular synthesized silver nanoparticles from marine Streptomyces rochei MHM13. Egypt. J. Aquat. Res. 2016, 42, 301–312. [Google Scholar] [CrossRef]
- Prakash, A.; Sharma, S.; Ahmad, N.; Ghosh, A.; Sinha, P. Bacteria mediated extracellular synthesis of metallic nanoparticles. Int. Res. J. Biotechnol. 2010, 1, 71–79. Available online: https://www.interesjournals.org/articles/bacteria-mediated-extracellular-synthesis-of-metallic-nanoparticles.pdf (accessed on 8 May 2025).
- Liu, L.; Liu, T.; Tade, M.; Wang, S.; Li, X.; Liu, S. Less is more, greener microbial synthesis of silver nanoparticles. Enzyme Microb. Technol. 2014, 67, 53–58. [Google Scholar] [CrossRef] [PubMed]
- Sintubin, L.; De Windt, W.; Dick, J.; Mast, J.; van der Ha, D.; Verstraete, W.; Boon, N. Lactic acid bacteria as reducing and capping agent for the fast and efficient production of silver nanoparticles. Appl. Microbiol. Biotechnol. 2009, 84, 741–749. [Google Scholar] [CrossRef] [PubMed]
- Gondikas, A.P.; Morris, A.; Reinsch, B.C.; Marinakos, S.M.; Lowry, G.V.; Hsu-Kim, H. Cysteine-Induced Modifications of Zero-valent Silver Nanomaterials: Implications for Particle Surface Chemistry, Aggregation, Dissolution, and Silver Speciation. Environ. Sci. Technol. 2012, 46, 7037–7045. [Google Scholar] [CrossRef] [PubMed]
- Mariappan, Y.; Viswanathan, V.; Baskaralingam, V. Culinary spices mediated biogenesis of nanoparticles for cancer and diabetes treatment. Fundam. Bionanomaterials 2022, 59–76. [Google Scholar] [CrossRef]
- Bamal, D.; Singh, A.; Chaudhary, G.; Kumar, M.; Singh, M.; Rani, N.; Mundlia, P.; Sehrawat, A.R. Silver Nanoparticles Biosynthesis, Characterization, Antimicrobial Activities, Applications, Cytotoxicity and Safety Issues: An Updated Review. Nanomaterials 2021, 11, 2086. [Google Scholar] [CrossRef] [PubMed]
- Dakal, T.C.; Kumar, A.; Majumdar, R.S.; Yadav, V. Mechanistic Basis of Antimicrobial Actions of Silver Nanoparticles. Front. Microbiol. 2016, 7, 1831. [Google Scholar] [CrossRef] [PubMed]
- Casals, E.; Gusta, M.F.; Bastus, N.; Rello, J.; Puntes, V. Silver Nanoparticles and Antibiotics: A Promising Synergistic Approach to Multidrug-Resistant Infections. Microorganisms 2025, 13, 952. [Google Scholar] [CrossRef] [PubMed]
- Mijnendonckx, K.; Leys, N.; Mahillon, J.; Silver, S.; Van Houdt, R. Antimicrobial silver: Uses, toxicity and potential for resistance. BioMetals 2013, 26, 609–621. [Google Scholar] [CrossRef] [PubMed]
- Quinteros, M.A.; Aristizábal, V.C.; Dalmasso, P.R.; Paraje, M.G.; Páez, P.L. Oxidative stress generation of silver nanoparticles in three bacterial genera and its relationship with the antimicrobial activity. Toxicol. In Vitro 2016, 36, 216–223. [Google Scholar] [CrossRef] [PubMed]
- Randall, C.P.; Oyama, L.B.; Bostock, J.M.; Chopra, I.; O’Neill, A.J. The silver cation (Ag+): Antistaphylococcal activity, mode of action and resistance studies. J. Antimicrob. Chemother. 2012, 68, 131–138. [Google Scholar] [CrossRef] [PubMed]
- Pandian, S.R.K.; Deepak, V.; Kalishwaralal, K.; Viswanathan, P.; Gurunathan, S. Mechanism of bactericidal activity of Silver Nitrate—A concentration dependent bi-functional molecule. Braz. J. Microbiol. 2010, 41, 805–809. [Google Scholar] [CrossRef] [PubMed]
- Liao, C.; Li, Y.; Tjong, S. Bactericidal and Cytotoxic Properties of Silver Nanoparticles. Int. J. Mol. Sci. 2019, 20, 449. [Google Scholar] [CrossRef] [PubMed]
- Xiu, Z.; Zhang, Q.; Puppala, H.L.; Colvin, V.L.; Alvarez, P.J.J. Negligible Particle-Specific Antibacterial Activity of Silver Nanoparticles. Nano Lett. 2012, 12, 4271–4275. [Google Scholar] [CrossRef] [PubMed]
- Monchy, S.; Benotmane, M.A.; Janssen, P.; Vallaeys, T.; Taghavi, S.; van der Lelie, D.; Mergeay, M. Plasmids pMOL28 and pMOL30 of Cupriavidus metallidurans Are Specialized in the Maximal Viable Response to Heavy Metals. J. Bacteriol. 2007, 189, 7417–7425. [Google Scholar] [CrossRef] [PubMed]
- Rensing, C.; Grass, G. Escherichia coli mechanisms of copper homeostasis in a changing environment. FEMS Microbiol Rev. 2003, 27, 197–213. [Google Scholar] [CrossRef] [PubMed]
- Silver, S.; Phung, L.T. Bacterial Heavy Metal Resistance: New Surprises. Annu. Rev. Microbiol. 1996, 50, 753–789. [Google Scholar] [CrossRef] [PubMed]
- Nies, D.H. Efflux-mediated heavy metal resistance in prokaryotes. FEMS Microbiol Rev. 2003, 27, 313–339. [Google Scholar] [CrossRef] [PubMed]
- Gupta, A.; Matsui, K.; Lo, J.-F.; Silver, S. Molecular basis for resistance to silver cations in Salmonella. Nat. Med. 1999, 5, 183–188. [Google Scholar] [CrossRef] [PubMed]
- Silver, S.; Phung, L.T.; Silver, G. Silver as biocides in burn and wound dressings and bacterial resistance to silver compounds. J. Ind. Microbiol. Biotechnol. 2006, 33, 627–634. [Google Scholar] [CrossRef] [PubMed]
- Franke, S.; Grass, G.; Rensing, C.; Nies, D.H. Molecular Analysis of the Copper-Transporting Efflux System CusCFBA of Escherichia coli. J. Bacteriol. 2003, 185, 3804–3812. [Google Scholar] [CrossRef] [PubMed]
- Su, C.-C.; Long, F.; Yu, E.W. The Cus efflux system removes toxic ions via a methionine shuttle. Protein Sci. 2010, 20, 6–18. [Google Scholar] [CrossRef] [PubMed]
- Gaurav, A.; Bakht, P.; Saini, M.; Pandey, S.; Pathania, R. Role of bacterial efflux pumps in antibiotic resistance, virulence, and strategies to discover novel efflux pump inhibitors. Microbiology 2023, 169, 001333. [Google Scholar] [CrossRef] [PubMed]
- Li, H.; Xu, H. Mechanisms of bacterial resistance to environmental silver and antimicrobial strategies for silver: A review. Environ. Res. 2024, 248, 118313. [Google Scholar] [CrossRef] [PubMed]
- Mikhailova, E.O. Green Silver Nanoparticles: An Antibacterial Mechanism. Antibiotics 2024, 14, 5. [Google Scholar] [CrossRef] [PubMed]
- Singh, R.; Shedbalkar, U.U.; Wadhwani, S.A.; Chopade, B.A. Bacteriagenic silver nanoparticles: Synthesis, mechanism, and applications. Appl. Microbiol. Biotechnol. 2015, 99, 4579–4593. [Google Scholar] [CrossRef] [PubMed]
- Narayanan, K.B.; Sakthivel, N. Biological synthesis of metal nanoparticles by microbes. Adv. Colloid Interface Sci. 2010, 156, 1–13. [Google Scholar] [CrossRef] [PubMed]
- Ghosh, S.; Ahmad, R.; Zeyaullah, M.; Khare, S.K. Microbial Nano-Factories: Synthesis and Biomedical Applications. Front. Chem. 2021, 9, 626834. [Google Scholar] [CrossRef] [PubMed]
- Wadhwani, S.A.; Shedbalkar, U.U.; Singh, R.; Karve, M.; Chopade, B.A. Chopade Novel polyhedral gold nanoparticles: Green synthesis, optimization and characterization by environmental isolate of Acinetobacter sp. SW30. World J. Microbiol. Biotechnol. 2014, 30, 2723–2731. [Google Scholar] [CrossRef] [PubMed]
- Srivastava, P.; Bragança, J.; Ramanan, S.R.; Kowshik, M. Synthesis of silver nanoparticles using haloarchaeal isolate Halococcus salifodinae BK3. Extremophiles 2013, 17, 821–831. [Google Scholar] [CrossRef] [PubMed]
- Durán, N.; Marcato, P.D.; Alves, O.L.; De Souza, G.I.H.; Esposito, E. Mechanistic Aspects of Biosynthesis of Silver Nanoparticles by Several Fusarium Oxysporum Strains. J. Nanobiotechnology 2005, 3, 8. [Google Scholar] [CrossRef] [PubMed]
- Parikh, R.Y.; Singh, S.; Prasad, B.L.V.; Patole, M.S.; Sastry, M.; Shouche, Y.S. Extracellular Synthesis of Crystalline Silver Nanoparticles and Molecular Evidence of Silver Resistance from Morganella sp.: Towards Understanding Biochemical Synthesis Mechanism. ChemBioChem 2008, 9, 1415–1422. [Google Scholar] [CrossRef] [PubMed]
- Coelho, C.; Romão, M.J. Structural and mechanistic insights on nitrate reductases. Protein Sci. 2015, 24, 1901–1911. [Google Scholar] [CrossRef] [PubMed]
- Kumar, S.A.; Abyaneh, M.K.; Gosavi, S.W.; Kulkarni, S.K.; Pasricha, R.; Ahmad, A.; Khan, M.I. Nitrate reductase-mediated synthesis of silver nanoparticles from AgNO3. Biotechnol. Lett. 2007, 29, 439–445. [Google Scholar] [CrossRef] [PubMed]
- Velmurugan, P.; Iydroose, M.; Mohideen, M.H.A.K.; Mohan, T.S.; Cho, M.; Oh, B.-T. Biosynthesis of silver nanoparticles using Bacillus subtilis EWP-46 cell-free extract and evaluation of its antibacterial activity. Bioprocess Biosyst Eng. 2014, 37, 1527–1534. [Google Scholar] [CrossRef] [PubMed]
- Dinesh, R.A.; Raja, S.; Kishanlal, N.; Nachiyar, C.V.; Sunkar, S. Microbe-Based Synthesis of Gold Nanoparticles and its Catalytic Applications. Biosci Biotechnol Res. Asia 2023, 20, 511–527. [Google Scholar] [CrossRef]
- Lin, I.W.-S.; Lok, C.-N.; Che, C.-M. Biosynthesis of silver nanoparticles from silver(<scp>i</scp>) reduction by the periplasmic nitrate reductase c-type cytochrome subunit NapC in a silver-resistant E. coli. Chem. Sci. 2014, 5, 3144–3150. [Google Scholar] [CrossRef]
- Wang, H.; Law, N.; Pearson, G.; van Dongen, B.E.; Jarvis, R.M.; Goodacre, R.; Lloyd, J.R. Impact of silver(I) on the metabolism of Shewanella oneidensis. J Bacteriol. 2010, 192, 1143–1150. [Google Scholar] [CrossRef] [PubMed]
- Egwu, C.O.; Aloke, C.; Onwe, K.T.; Umoke, C.I.; Nwafor, J.; Eyo, R.A.; Chukwu, J.A.; Ufebe, G.O.; Ladokun, J.; Audu, D.T.; et al. Nanomaterials in Drug Delivery: Strengths and Opportunities in Medicine. Molecules 2024, 29, 2584. [Google Scholar] [CrossRef] [PubMed]
- Öztürk, K.; Kaplan, M.; Çalış, S. Effects of nanoparticle size, shape, and zeta potential on drug delivery. Int. J. Pharm. 2024, 666, 124799. [Google Scholar] [CrossRef] [PubMed]
- Yusuf, A.; Almotairy, A.R.Z.; Henidi, H.; Alshehri, O.Y.; Aldughaim, M.S. Nanoparticles as Drug Delivery Systems: A Review of the Implication of Nanoparticles’ Physicochemical Properties on Responses in Biological Systems. Polymers 2023, 15, 1596. [Google Scholar] [CrossRef] [PubMed]
- Hoshyar, N.; Gray, S.; Han, H.; Bao, G. The Effect of Nanoparticle Size on In Vivo Pharmacokinetics and Cellular Interaction. Nanomedicine 2016, 11, 673–692. [Google Scholar] [CrossRef] [PubMed]
- El-Kheshen, A.A.; El-Rab, S.F.G. Effect of reducing and protecting agents on size of silver nanoparticles and their anti-bacterial activity. Der Pharma Chem. 2012, 4, 53–65. Available online: http://www.derpharmachemica.com/ (accessed on 5 May 2025).
- Li, Y.; Kröger, M.; Liu, W.K. Shape effect in cellular uptake of PEGylated nanoparticles: Comparison between sphere, rod, cube and disk. Nanoscale 2015, 7, 16631–16646. [Google Scholar] [CrossRef] [PubMed]
- Gratton, S.E.A.; Ropp, P.A.; Pohlhaus, P.D.; Luft, J.C.; Madden, V.J.; Napier, M.E.; DeSimone, J.M. The effect of particle design on cellular internalization pathways. Proc. Natl. Acad. Sci. USA 2008, 105, 11613–11618. [Google Scholar] [CrossRef] [PubMed]
- Zhang, P.; Xia, J.; Luo, S. Generation of Well-Defined Micro/Nanoparticles via Advanced Manufacturing Techniques for Therapeutic Delivery. Materials 2018, 11, 623. [Google Scholar] [CrossRef] [PubMed]
- Hajfathalian, M.; Mossburg, K.J.; Radaic, A.; Woo, K.E.; Jonnalagadda, P.; Kapila, Y.; Bollyky, P.L.; Cormode, D.P. A review of recent advances in the use of complex metal nanostructures for biomedical applications from diagnosis to treatment. WIREs Nanomed. Nanobiotechnol. 2024, 16, e1959. [Google Scholar] [CrossRef] [PubMed]
- Slavin, Y.N.; Asnis, J.; Häfeli, U.O.; Bach, H. Metal nanoparticles: Understanding the mechanisms behind antibacterial activity. J. Nanobiotechnol. 2017, 15, 65. [Google Scholar] [CrossRef] [PubMed]
- Tang, J.; Hao, J.H.; Wang, X.W.; Niu, L.L.; Zhu, N.L.; Li, Z.G.; Li, L.X.Y.; Wang, Y.W.; Jiang, G.B. Mechanisms for facet-dependent biological effects and environmental risks of engineered nanoparticles: A review. Environ. Sci. Nano 2025, 12, 3413–3424. [Google Scholar] [CrossRef]
- Rojas-Andrade, M.; Cho, A.T.; Hu, P.G.; Lee, S.J.; Deming, C.P.; Sweeney, S.W.; Saltikov, C.; Chen, S.W. Enhanced antimicrobial activity with faceted silver nanostructures. J. Mater. Sci. 2015, 50, 2849–2858. [Google Scholar] [CrossRef]
- Cheon, J.Y.; Kim, S.J.; Rhee, Y.H.; Kwon, O.H.; Park, W.H. Shape-dependent antimicrobial activities of silver nanoparticles. Int. J. Nanomed. 2019, 14, 2773–2780. [Google Scholar] [CrossRef] [PubMed]
- Giri, N.; Natarajan, R.K.; Gunasekaran, S.; Shreemathi, S. 13C NMR and FTIR spectroscopic study of blend behavior of PVP and nano silver particles. Arch. Appl. Sci. Res. 2025, 3, 1–5. Available online: https://www.scholarsresearchlibrary.com/abstract/13c-nmr-and-ftir-spectroscopic-study-of-blend-behavior-of-pvprnand-nano-silver-particles-11253.html (accessed on 8 May 2025).
- Shroff, S. Exploring the Antibacterial Property of Silver Nanotriangles Synthesized Using Biocompatible Polymers. Master’s Thesis, University of Jyväskylä, Jyväskylä, Finland, February 2018. Available online: https://urn.fi/URN:NBN:fi:jyu-201805252766 (accessed on 8 May 2025).
- Pal, S.; Tak, Y.K.; Song, J.M. Does the Antibacterial Activity of Silver Nanoparticles Depend on the Shape of the Nanoparticle? A Study of the Gram-Negative Bacterium Escherichia coli. Appl. Environ. Microbiol 2007, 73, 1712–1720. [Google Scholar] [CrossRef] [PubMed]
- Hong, X.; Wen, J.; Xiong, X.; Hu, Y. Shape effect on the antibacterial activity of silver nanoparticles synthesized via a microwave-assisted method. Environ. Sci. Pollut. Res. 2015, 23, 4489–4497. [Google Scholar] [CrossRef] [PubMed]
- Xu, R.; Wang, D.; Zhang, J.; Li, Y. Shape-Dependent Catalytic Activity of Silver Nanoparticles for the Oxidation of Styrene. Chem. -Asian J. 2006, 1, 888–893. [Google Scholar] [CrossRef] [PubMed]
- Khodashenas, B.; Ghorbani, H.R. Synthesis of silver nanoparticles with different shapes. Arab. J. Chem. 2019, 12, 1823–1838. [Google Scholar] [CrossRef]
- Khan, S.; Ahmad, K.; Ahmad, A.; Raish, M.; Jan, B.L.; Khan, A.; Khan, M.S. Biogenic pentagonal silver nanoparticles for safer and more effective antibacterial therapeutics. Int. J. Nanomed. 2018, 13, 7789–7799. [Google Scholar] [CrossRef] [PubMed]
- Acharya, D.; Singha, K.M.; Pandey, P.; Mohanta, B.; Rajkumari, J.; Singha, L.P. Shape dependent physical mutilation and lethal effects of silver nanoparticles on bacteria. Sci. Rep. 2018, 8, 201. [Google Scholar] [CrossRef] [PubMed]
- Barroso, L.G.R.; Garcia, E.L.; Mojicevic, M.; Huerta, M.; Pogue, R.; Devine, D.M.; Brennan-Fournet, M. Triangular Silver Nanoparticles Synthesis: Investigating Potential Application in Materials and Biosensing. Appl. Sci. 2023, 13, 8100. [Google Scholar] [CrossRef]
- Kumari, M.; Pandey, S.; Giri, V.P.; Bhattacharya, A.; Shukla, R.; Mishra, A.; Nautiyal, C.S. Tailoring shape and size of biogenic silver nanoparticles to enhance antimicrobial efficacy against MDR bacteria. Microb. Pathog. 2017, 105, 346–355. [Google Scholar] [CrossRef] [PubMed]
- Choi, O.; Hu, Z. Size Dependent and Reactive Oxygen Species Related Nanosilver Toxicity to Nitrifying Bacteria. Environ. Sci. Technol. 2008, 42, 4583–4588. [Google Scholar] [CrossRef] [PubMed]
- Panyala, N.R.; Peña-Méndez, E.M.; Havel, J. Silver or silver nanoparticles: A hazardous threat to the environment and human health? J. Appl. Biomed. 2008, 6, 117–129. [Google Scholar] [CrossRef]
- Nandhini, J.; Karthikeyan, E.; Rani, E.E.; Karthikha, V.S.; Sanjana, D.S.; Jeevitha, H.; Rajeshkumar, S.; Venugopal, V.; Priyadharshan, A. Advancing engineered approaches for sustainable wound regeneration and repair: Harnessing the potential of green synthesized silver nanoparticles. Eng. Regen. 2024, 5, 306–325. [Google Scholar] [CrossRef]
- Fayaz, A.M.; Balaji, K.; Girilal, M.; Yadav, R.; Kalaichelvan, P.T.; Venketesan, R. Biogenic synthesis of silver nanoparticles and their synergistic effect with antibiotics: A study against gram-positive and gram-negative bacteria. Nanomedicine 2010, 6, 103–109. [Google Scholar] [CrossRef] [PubMed]
- Sheikpranbabu, S.; Kalishwaralal, K.; Venkataraman, D.; Eom, S.H.; Park, J.; Gurunathan, S. Silver nanoparticles inhibit VEGF-and IL-1β-induced vascular permeability via Src dependent pathway in porcine retinal endothelial cells. J. Nanobiotechnol. 2009, 7, 8. [Google Scholar] [CrossRef] [PubMed]
- Gurunathan, S.; Han, J.W.; Dayem, A.A.; Eppakayala, V.; Park, J.H.; Cho, S.G.; Lee, K.J.; Kim, J.H. Green synthesis of anisotropic silver nanoparticles and its potential cytotoxicity in human breast cancer cells (MCF-7). J. Ind. Eng. Chem. 2013, 19, 1600–1605. [Google Scholar] [CrossRef]
- Alharbi, N.S.; Alsubhi, N.S. Green synthesis and anticancer activity of silver nanoparticles prepared using fruit extract of Azadirachta indica. J. Radiat Res. Appl. Sci. 2022, 15, 335–345. [Google Scholar] [CrossRef]
- Pasha, A.; Kumbhakar, D.V.; Sana, S.S.; Ravinder, D.; Lakshmi, B.V.; Kalangi, S.K.; Pawar, S.C. Role of Biosynthesized Ag-NPs Using Aspergillus niger (MK503444.1) in Antimicrobial, Anti-Cancer and Anti-Angiogenic Activities. Front. Pharmacol. 2022, 12, 812474. [Google Scholar] [CrossRef] [PubMed]
- Jadhav, K.; Deore, S.; Dhamecha, D.; H, R.R.; Jagwani, S.; Jalalpure, S.; Bohara, R. Phytosynthesis of Silver Nanoparticles: Characterization, Biocompatibility Studies, and Anticancer Activity. ACS Biomater. Sci. Eng. 2018, 4, 892–899. [Google Scholar] [CrossRef] [PubMed]
- Kah, G.; Chandran, R.; Abrahamse, H. Green silver nanoparticles curcumin conjugate induced photodynamic therapy of lung cancer and lung cancer stem cells. RSC. Adv. 2025, 15, 5020–5041. [Google Scholar] [CrossRef] [PubMed]
- Ratan, Z.A.; Haidere, M.F.; Nurunnabi, M.; Shahriar, S.M.; Ahammad, A.J.S.; Shim, Y.Y.; Reaney, M.J.T.; Cho, J.Y. Green Chemistry Synthesis of Silver Nanoparticles and Their Potential Anticancer Effects. Cancers 2020, 12, 855. [Google Scholar] [CrossRef] [PubMed]
- Wei, W.; Zhang, X.; Chen, X.; Zhou, M.; Xu, R.; Zhang, X. Smart surface coating of drug nanoparticles with cross-linkable polyethylene glycol for bio-responsive and highly efficient drug delivery. Nanoscale 2016, 8, 8118–8125. [Google Scholar] [CrossRef] [PubMed]
- Akter, M.; Sikder, M.T.; Rahman, M.M.; Ullah, A.K.M.A.; Hossain, K.F.B.; Banik, S.; Hosokawa, T.; Saito, T.; Kurasaki, M. A systematic review on silver nanoparticles-induced cytotoxicity: Physicochemical properties and perspectives. J. Adv. Res. 2018, 9, 1–16. [Google Scholar] [CrossRef] [PubMed]
- Chen, Z.; Xie, S.B.; Shen, L.; Du, Y.; He, S.L.; Li, Q.; Liang, Z.W.; Meng, X.; Li, B.; Xu, X.D.; et al. Investigation of the interactions between silver nanoparticles and Hela cells by scanning electrochemical microscopy. Analyst 2008, 133, 1221. [Google Scholar] [CrossRef] [PubMed]
- Haidari, H.; Kopecki, Z.; Sutton, A.T.; Garg, S.; Cowin, A.J.; Vasilev, K. pH-Responsive ‘Smart’ Hydrogel for Controlled Delivery of Silver Nanoparticles to Infected Wounds. Antibiotics 2021, 10, 49. [Google Scholar] [CrossRef] [PubMed]
- Jayan, H.; Zhou, R.Y.; Zheng, Y.X.; Xue, S.S.; Yin, L.M.; El-Seedi, H.R.; Zou, X.B.; Guo, Z.M. Microfluidic-SERS platform with in-situ nanoparticle synthesis for rapid E. coli detection in food. Food Chem. 2025, 471, 142800. [Google Scholar] [CrossRef] [PubMed]
- Morones, J.R.; Elechiguerra, J.L.; Camacho, A.; Holt, K.; Kouri, J.B.; Ramírez, J.T.; Yacaman, M.J. The bactericidal effect of silver nanoparticles. Nanotechnology 2005, 16, 2346–2353. [Google Scholar] [CrossRef] [PubMed]
- Sati, A.; Ranade, T.N.; Mali, S.N.; Yasin, A.; Pratap, A. Silver Nanoparticles (AgNPs): Comprehensive Insights into Bio/Synthesis, Key Influencing Factors, Multifaceted Applications, and Toxicity─A 2024 Update. ACS Omega 2025, 10, 7549–7582. [Google Scholar] [CrossRef] [PubMed]
- Schluesener, J.K.; Schluesener, H.J. Nanosilver: Application and novel aspects of toxicology. Arch. Toxicol. 2013, 87, 569–576. [Google Scholar] [CrossRef] [PubMed]
- Pratsinis, A.; Hervella, P.; Leroux, J.; Pratsinis, S.E.; Sotiriou, G.A. Toxicity of Silver Nanoparticles in Macrophages. Small 2013, 9, 2576–2584. [Google Scholar] [CrossRef] [PubMed]
- Wei, L.; Lu, J.; Xu, H.; Patel, A.; Chen, Z.-S.; Chen, G. Silver nanoparticles: Synthesis, properties, and therapeutic applications. Drug Discov. Today 2015, 20, 595–601. [Google Scholar] [CrossRef] [PubMed]
- Vrček, I.V.; Zuntar, I.; Petlevski, R.; Pavicic, I.; Dutour Sikiric, M.; Curlin, M.; Goessler, W. Comparison of in vitro toxicity of silver ions and silver nanoparticles on human hepatoma cells. Environ. Toxicol. 2016, 31, 679–692. [Google Scholar] [CrossRef] [PubMed]
- Wen, Y.; Geitner, N.K.; Chen, R.; Ding, F.; Chen, P.Y.; Andorfer, R.E.; Govindan, P.N.; Ke, P.C. Binding of cytoskeletal proteins with silver nanoparticles. RSC. Adv. 2013, 3, 22002. [Google Scholar] [CrossRef]
- Jaswal, T.; Gupta, J. A review on the toxicity of silver nanoparticles on human health. Mater. Today Proc. 2013, 81, 859–863. [Google Scholar] [CrossRef]
- Zykova, M.V.; Karpova, M.R.; Zhang, Y.; Chubik, M.V.; Shunkova, D.M.; Azarkina, L.A.; Mihalyov, D.A.; Konstantinov, A.I.; Plotnikov, E.V.; Pestryakov, A.N.; et al. The Influence of Silver-Containing Bionanomaterials Based on Humic Ligands on Biofilm Formation in Opportunistic Pathogens. Nanomaterials 2024, 14, 1453. [Google Scholar] [CrossRef] [PubMed]
- Zykova, M.V.; Volikov, A.B.; Buyko, E.E.; Bratishko, K.A.; Ivanov, V.V.; Konstantinov, A.I.; Logvinova, L.A.; Mihalyov, D.A.; Sobolev, N.A.; Zhirkova, A.M.; et al. Enhanced Antioxidant Activity and Reduced Cytotoxicity of Silver Nanoparticles Stabilized by Different Humic Materials. Polymers 2023, 15, 3386. [Google Scholar] [CrossRef] [PubMed]
- Liu, W.J.; Wang, A.F.; Li, X.T.; Wang, J.S.; Liu, X.W.; Zhao, Y.J.; He, Z.Y.; Du, J.J. Multi-omics analysis for mechanistic understanding of microbial-mediated synthesis of silver nanoparticles. Chem. Eng. J. 2024, 497, 154410. [Google Scholar] [CrossRef]

| Biosynthetic Method | Advantages | Disadvantages | Differences in Formed NPs | Ref. |
|---|---|---|---|---|
| Plant-Mediated Synthesis | - Simple and cost-effective - Eco-friendly, eliminates hazardous chemicals - Uses renewable resources (i.e., plant extracts) - High stability due to phytochemicals (flavonoids, terpenoids, phenolics) acting as reducing/capping agents - Scalable and reproducible | - Variability in extract composition due to plant species, geographical sources, and seasonal changes - Challenges in standardising extracts | - Size: 10–50 nm - Mostly spherical morphology - Potent antimicrobial and anticancer activity - Enhanced stability due to natural capping agents | [12,26,27] |
| Microbial-Based Synthesis | - Tailored properties via microbial metabolism - High yields with fungi (e.g., Fusarium oxysporum) - Natural capping agents from algae reduce aggregation - Antibacterial and anticancer effects | - Limited scalability due to controlled culture conditions (pH, temperature, nutrients) - Higher cost compared to plant-mediated synthesis - Optimisation needed for industrial-scale production | - Variable size and morphology depending on microorganism - Extracellular or intracellular synthesis - Enhanced antibacterial properties with optimised conditions | [13,21,28,29,30] |
| Biomolecule-Based Synthesis | - Precise control over particle size, morphology, and function - Enhanced biocompatibility (e.g., chitosan-stabilised AgNPs; humic ligands as reducing/stabilising agents) - Suitable for specific applications (e.g., drug delivery) | - Limited by availability and cost of purified biomolecules - Scalability challenges due to biomolecule production costs | - Highly controlled size and morphology - Stabilised by proteins or polysaccharides - Tailored for biomedical applications | [16,20,31,32] |
| Advantage | Challenges |
|---|---|
| Advanced drug stability | Scale-up |
| Improved drug solubility | Lack of guidelines for biological testing |
| Extended drug circulation time | High production costs |
| Drug targeting (Increased drug concentration in target tissues) | Heterogenicity of diseases |
| Slowed down drug metabolism | Cytotoxicity |
| Drug accumulation | Variability of elimination and metabolism |
| Increased bioavailability | Complexity of dual drug-loaded or stimuli responsive nanosystems |
| Minimising side effects | Lack of reproducibility |
| Controlled and triggered release | Long-term stability |
| Combination therapy | Low clinical translation |
| Theranostic effect | Triggering of Immune response |
| Improving patient compliance |
| Microorganisms | ||||||
| Erythromycin (10 μg/disk) | Kanamycin (10 μg/disk) | |||||
| Zone (mm) | Fold increase %= ((b − a)/a) × 100 | Zone (mm) | Fold increase %= ((b − a)/a) × 100 | |||
| Erythromycin (a) | Ag-NPs + Erythromycin (b) | Kanamycin (a) | Ag-NPs + Kanamycin (b) | |||
| E. coli | 13 | 16 | 23.08 | 12 | 16 | 33.33 |
| S. typhi | 24 | 31 | 29.17 | 13 | 19 | 46.15 |
| S. aureus | 9 | 10 | 11.11 | 9 | 11 | 22.22 |
| M. luteus | 8 | 9 | 12.50 | 10 | 11 | 10.00 |
| Overall synergistic antibacterial effect (%) | 18.96 | Overall synergistic antibacterial effect (%) | 27.93 | |||
| Microorganisms | ||||||
| Chloramphenicol (10 μg/disk) | Ampicillin (10 μg/disk) | |||||
| Zone (mm) | Fold increase %= ((b − a)/a) × 100 | Zone (mm) | Fold increase %= ((b − a)/a) × 100 | |||
| Chloramphenicol (a) | AgNPs + chloramphenicol (b) | Ampicillin (a) | AgNPs + Ampicillin (b) | |||
| E. coli | 22 | 28 | 27.27 | 12 | 21 | 75.00 |
| S. typhi | 29 | 36 | 24.14 | 11 | 20 | 81.82 |
| S. aureus | 9 | 10 | 11.11 | 11 | 19 | 72.73 |
| M. luteus | 10 | 11 | 10.00 | 10 | 17 | 70.00 |
| Overall synergistic antibacterial effect (%) | 18.13 | Overall synergistic antibacterial effect (%) | 74.89 | |||
Disclaimer/Publisher’s Note: The statements, opinions and data contained in all publications are solely those of the individual author(s) and contributor(s) and not of MDPI and/or the editor(s). MDPI and/or the editor(s) disclaim responsibility for any injury to people or property resulting from any ideas, methods, instructions or products referred to in the content. |
© 2025 by the authors. Licensee MDPI, Basel, Switzerland. This article is an open access article distributed under the terms and conditions of the Creative Commons Attribution (CC BY) license (https://creativecommons.org/licenses/by/4.0/).
Share and Cite
Jiang, X.; Khan, S.; Dykes, A.; Stulz, E.; Zhang, X. Biogenic Synthesis of Silver Nanoparticles and Their Diverse Biomedical Applications. Molecules 2025, 30, 3104. https://doi.org/10.3390/molecules30153104
Jiang X, Khan S, Dykes A, Stulz E, Zhang X. Biogenic Synthesis of Silver Nanoparticles and Their Diverse Biomedical Applications. Molecules. 2025; 30(15):3104. https://doi.org/10.3390/molecules30153104
Chicago/Turabian StyleJiang, Xiaokun, Shamma Khan, Adam Dykes, Eugen Stulz, and Xunli Zhang. 2025. "Biogenic Synthesis of Silver Nanoparticles and Their Diverse Biomedical Applications" Molecules 30, no. 15: 3104. https://doi.org/10.3390/molecules30153104
APA StyleJiang, X., Khan, S., Dykes, A., Stulz, E., & Zhang, X. (2025). Biogenic Synthesis of Silver Nanoparticles and Their Diverse Biomedical Applications. Molecules, 30(15), 3104. https://doi.org/10.3390/molecules30153104

